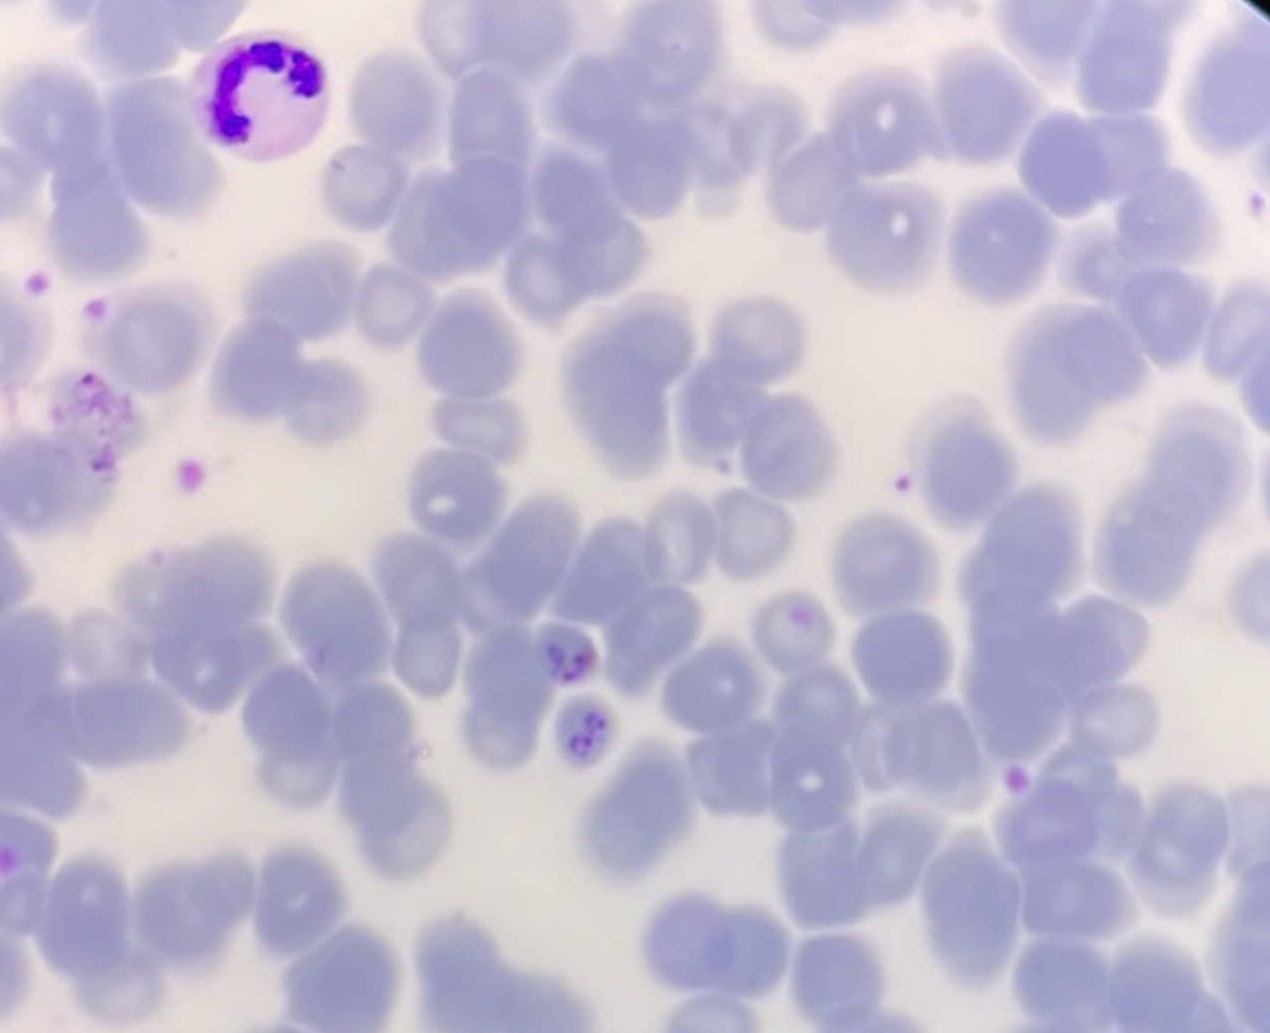
Test results of a patient with malaria. Photo: CDC Quang Binh

Threat to the survival of native species
From January 2022 to October 2024 alone, ENV recorded 471 cases with 1,759 violations related to advertising and trading of 45,307 exotic individuals.
Commonly trafficked exotic species include: Sul-cata-ta tortoises, red-eared sliders, lizards, snakes, small mammals and parrots. Most of these species are smuggled into Vietnam from foreign countries or come from unlicensed breeding facilities and pet hobbyists.
According to ENV data, reptiles account for 82% of illegally traded exotic animals, with 37,048 exotic turtles, snakes and lizards for sale. Birds account for 9% and other small mammals account for about 4% of all trafficked exotic animals.
Red-eared sliders and South American dragons are two of the most commonly traded alien species in Vietnam. Listed as one of the most invasive alien species in the world under Circular No. 35/2018/TT-BTNMT of the Ministry of Natural Resources and Environment, red-eared sliders are known to be one of the most invasive species in the world. Meanwhile, South American dragons are another species of concern. South American dragon populations have grown rapidly in many countries that are not the species’ natural range.
One of the main concerns with the trade in exotic species is their potential to establish wild populations when they are released into the environment or escape. This can pose a serious threat to native species as they compete with native species for food and habitat, disrupting the structure and balance of ecosystems.
Recently, at least one facility in Ho Chi Minh City has been licensed to commercially breed South American dragons, although the Vietnamese CITES Scientific Authorities have not confirmed that breeding this species does not negatively affect native species.
Meanwhile, in Dong Thap, in a recent case, instead of transferring 80 South American dragons and 9 Tegu lizards that were confiscated to a rescue center or zoo, the provincial Forest Protection Department auctioned these individuals to the very person who was discovered smuggling them. The subject is currently in the process of registering the breeding facility code.
Potential risks to human health
According to experts, the major challenge facing Vietnam in the context of the rapidly increasing illegal trade of exotic species is the lack of clear regulations and effective management systems to control the rapid growth of the exotic pet trade market and commercial breeding facilities for these species, which are urgent issues that need to be addressed.
“Allowing the commercial trade and breeding of exotic species without a strict management mechanism will set a bad precedent and cause many difficulties for law enforcement by authorities,” said Ms. Bui Thi Ha, Deputy Director of ENV.
Ms. Ha also said that controlling the illegal trade of alien species is very important to eliminate potential risks to human health. The world has recorded many pandemics originating from wild animals such as AIDS, SARS, influenza A/H5N1, Ebola, rabies and most likely COVID-19.
“We hope that the authorities will quickly step in to strengthen management and supervision to control the trade of exotic species that is increasing rapidly in Vietnam while this activity is still under control.
No one wants this situation to grow and become a crisis that requires a lot of time and resources to address its impacts on biodiversity, risks to human health and the safety of endangered species globally," said Ms. Ha.
ENV calls on people not to trade, transport or keep exotic wildlife species of unknown origin to prevent negative impacts of this activity on the ecosystem, contribute to protecting our own health and avoid unfortunate legal risks.